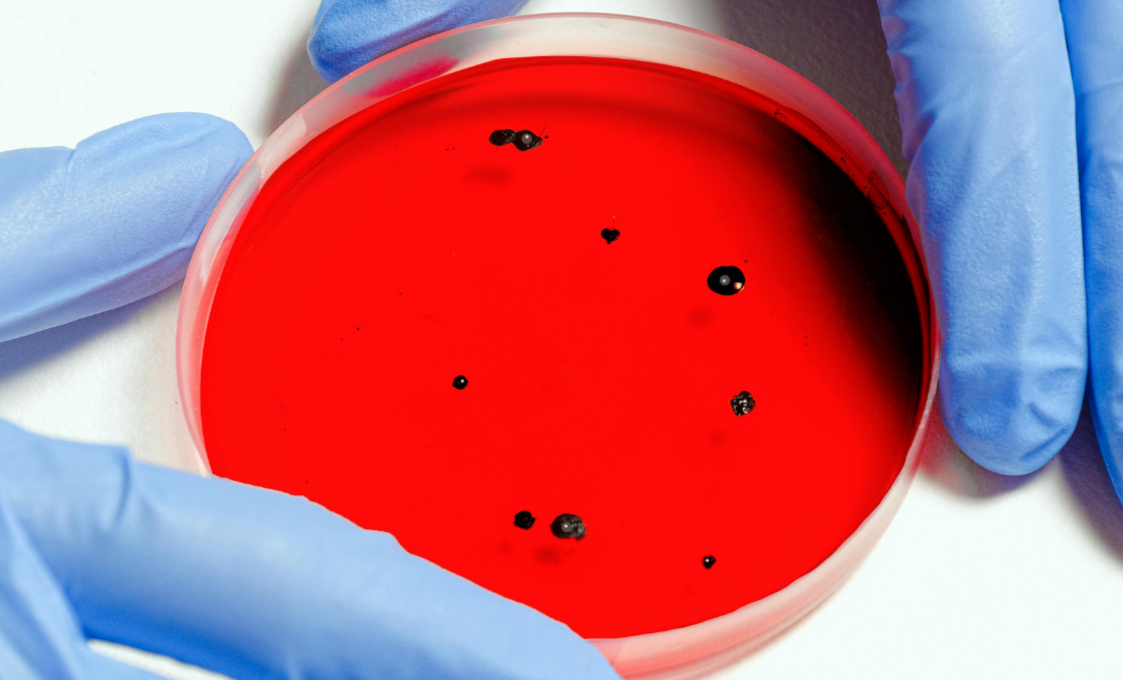

Больницы Ливана после взрывов пейджеров переполнены сотнями людей с ранениями глаз и лица — пострадавших так много, что в стране не хватает глазных хирургов. Характер ранений объяснил газете The New York Times член Корпуса стражей исламской революции (КСИР) Ирана.
Отмечается, что исламское движение «Хезболла» годами использовало пейджеры, чтобы затруднить перехват сообщений. В день происшествия на устройство поступило сообщение, которое, по словам двух чиновников, знакомых с ситуацией, выглядело так, как будто исходило от руководства «Хезболлы». Пейджеры пищали несколько секунд, прежде чем взорваться. Эти звуки заставили некоторых пострадавших поднести устройства близко к глазам и лицам, чтобы проверить сообщение, чем и вызваны травмы. Министр здравоохранения Ливана доктор Фирасс Абиад также заявил, что у многих пострадавших были травмы лица, особенно глаз, а также рук и живота. В результате детонации пейджеров по меньшей мере 11 человек не удалось спасти, ранения получили по меньшей мере 2700 человек.
Среди получивших ранения оказался посол Ирана в Ливане Моджтаба Амини. В результате детонации, как заявили в США, дипломат потерял один глаз и серьезно повредил другой. В то же время Иран поспешил опровергнуть эту информацию. В дипмиссии заявили, что процесс лечения посла Амани проходит хорошо, а публикации о его физическом состоянии и слепоте — ложь.
Врач, посетивший больницы в Сидоне, куда были доставлены некоторые из раненых, сказал, что из-за того, что так много человек получили ранения глаз, образовалась нехватка глазных хирургов. Врач Абдулрахман аль-Бизри заявил, что больницы, которые он посетил, были переполнены людьми с повреждениями глаз, лиц и рук, и медицинский персонал изо всех сил пытается вылечить их. «Травмы глаз будут нелегкими и потребуют длительного лечения», — отметил он. Раненых отправляют в медицинские учреждения за пределами Бейрута и его южных пригородов, где больницы переполнены.
Врачей в Ливан направил Иран. Глава Иранского общества Красного Полумесяца Пир Хосейн Коливанд заявил, что власти готовы транспортировать раненых в исламскую республику для лечения.